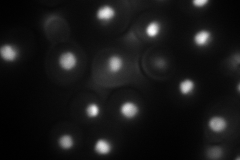

View description
Histone H2B, core histone protein required for chromatin assembly and chromosome function; nearly identical to HTB1; Rad6p-Bre1p-Lge1p mediated ubiquitination regulates transcriptional activation, meiotic DSB formation and H3 methylation
Localization:
Intensity:
Fold change:
Significance:
-
C’ GFP library in SD

nucleus845.83 -
N' NOP1pr-GFP in SD
nucleus150.018 -
N' TEF2pr-mCherry in SD

ER0 -
N' NATIVEpr-GFP in SD

nucleus283.101 -
N' TEF2pr-VC and Cyto-VN in SD

#N/A0 -
C’ GFP library in SD+DTT

nucleus653.550.77No -
C’ GFP library in SD+H2O2

nucleus591.30.69No -
C’ GFP library in Starvation Media

nucleus655.830.77No -
C’ GFP library on the background of Pup2-DaMP

nucleus -
C’ GFP library on the background of CCT mutant

nucleus653.560.772674No
